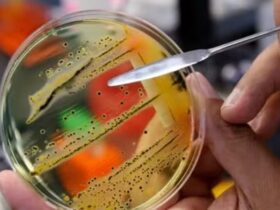

La Stratégie nationale portuaire du Sénégal (SNPS) fait l’objet d’un atelier de restitution. Cette importante rencontre de deux ...
Le gouverneur de la région de Thiès, M. Saer Ndao, a profité de la cérémonie de lancement officiel ...
Face à la montée de l’insécurité alimentaire dans plusieurs régions du pays, le ministère de la Famille et ...
Le Conseil d’administration de Sonatel a annoncé, ce jour, la nomination de M. Brelotte Ba au poste de ...
Ce mardi 22 juillet 2025, l’Académie nationale des sciences et techniques du Sénégal (ANSTS) et la Commission des ...
L’activiste et député Guy Marius Sagna a alerté sur des dysfonctionnements persistants dans la distribution d’intrants agricoles, notamment ...
Mouhamadou Lamine Badji, secrétaire général du syndicat des agents de la Sonatel était l’invité de l’émission matinale Salam ...
Depuis janvier 2025, l’administration américaine intensifie sa traque des migrants en situation irrégulière, avec plus de 1 500 ...
Au nom de l’Inspecteur Général Mame Seydou Ndour, Directeur Général de la Police nationale, le Commissaire Pape Mamadou ...
De la pauvreté extrême à une puissance mondiale : tel est le parcours fulgurant de la Chine, qui, ...